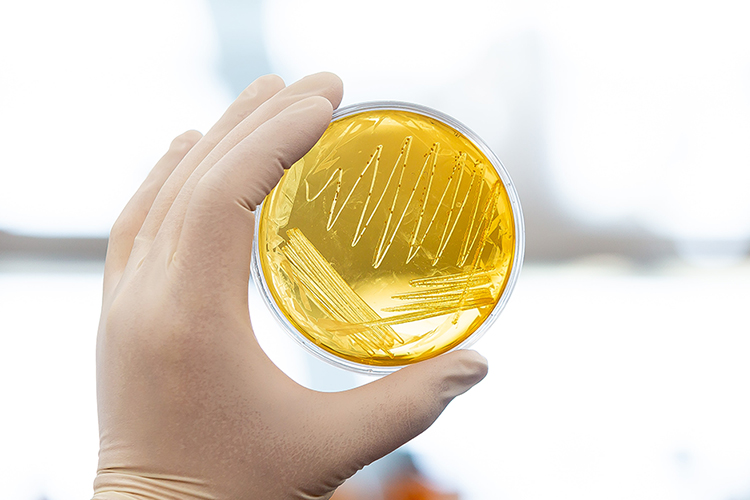
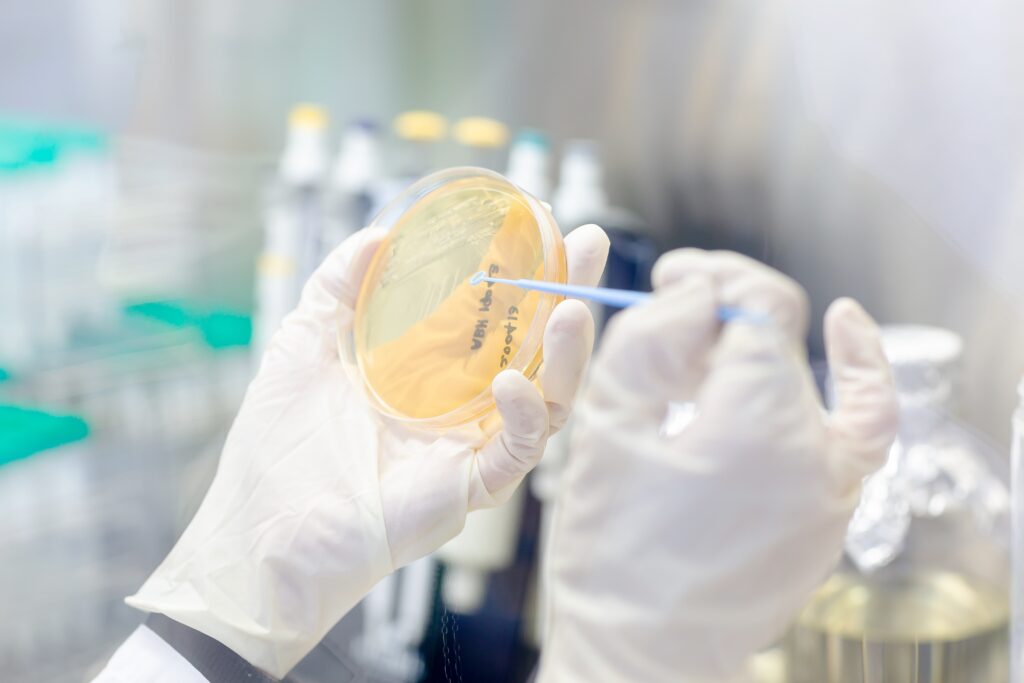
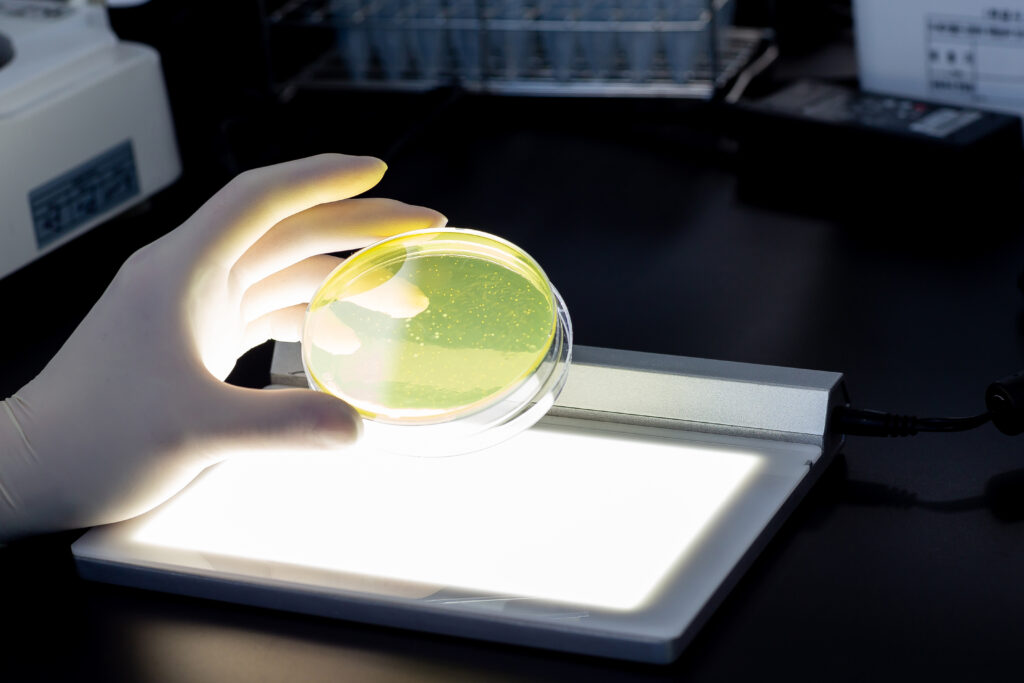

BNR Science
Restoring and Maintaining a
Healthy Balance in the Gut Microbiome
Why Probiotics?
Did you know that there are over 100 trillion bacteria living in a person's intestines?
The bacteria that inhabit a person’s digestive tracts are divided into three large groups:
In order to maintain a healthy balance of the intestinal microflora, it is important to increase beneficial bacteria and reduce harmful bacteria to create an intestinal environment in which the beneficial bacteria are dominant.
Probiotics Story
The word probiotics comes from the Latin preposition “pro” and the Greek word “biotic”, which together mean “for life”. Probiotics refer to the many beneficial bacteria that exist in our bodies. The most well known are Lactobacillus and Bifidobacterium.
In order to be approved as a probiotic, the bacteria must have a beneficial effect, not be toxic or pathogenic, and it is ideal to survive stomach acid and bile to reach the small intestines.
Probiotics Probiotics vs Lactic Acid Bacteria
While it may seem like all lactic acid bacteria are good for our bodies, there are some that are not beneficial, and some probiotics do not produce lactic acid; therefore probiotics and lactic acid bacteria cannot be described as the same.
Probiotics are Lactobacillus species that are beneficial to our bodies and help to create a healthy intestinal environment.
- Strengthens immunity through interactions with intestinal epithelial cells and intestinal bacteria
- Acidifies intestines through lactic acid production to suppress the growth of harmful bacteria that are weak against acid
- Induces proliferation of beneficial bacteria that grow well in acid
What is different about the proprietary Probiotic, Lactobacillus gasseri BNR17®?
Lactobacillus gasseri BNR17® is the first probiotic strain individually recognized by the Ministry of Food and Drug Safety (KFDA) as a functional ingredient to reduce body fat. Human clinical trials confirmed the ability of Lactobacillus gasseri BNR17® to reduce body fat. Lactobacillus gasseri BNR17®, a patented probiotic strain derived from human breast milk, adheres well to intestinal surfaces, helps with the proliferation of probiotics and suppression of bad bacteria, and promotes healthy bowel movement.

Quality Management
AceBiome only supplies products that have passed strict quality control.

AceBiome R&D Center
The AceBiome R&D Center is a corporate research institute approved by the Ministry of Science and Information and Communications Technology. We focus on screening and characterization of new probiotic strains and ingredients, efficacy evaluation and process development to develop innovative products.